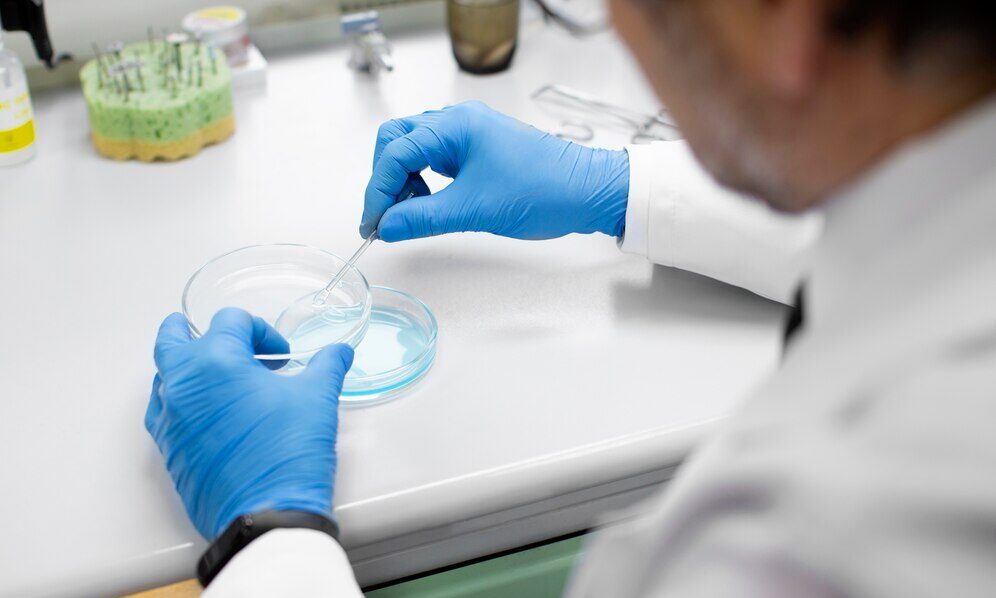

O que significa congelar espermatozoides?
O congelamento de espermatozoides, também conhecido como criopreservação de sêmen, é um método confiável e eficiente usado para guardar amostras de esperma com a intenção de usá-las mais tarde em tratamentos de reprodução assistida, como a inseminação intrauterina (IIU) ou a fertilização in vitro (FIV).
Quando a criopreservação de sêmen é sugerida?
Este procedimento é recomendado em várias circunstâncias, incluindo:
- Pacientes em tratamento contra o câncer:
Antes de começar a quimioterapia ou a radioterapia, é aconselhável armazenar o esperma, já que esses tratamentos podem prejudicar permanentemente a produção de espermatozoides e sua qualidade genética, mesmo depois de apenas uma sessão. - Homens que vão fazer vasectomia:
Guardar os espermatozoides antes da cirurgia é uma opção preventiva, evitando a necessidade de procedimentos futuros, caso haja arrependimento e vontade de ter filhos novamente. - Homens que querem postergar a paternidade:
A criopreservação também pode ser uma boa ideia para aqueles que planejam ter filhos mais tarde na vida. Isso ocorre porque, com o tempo, a qualidade do sêmen pode diminuir e o risco de alterações genéticas nos filhos pode aumentar.
Como é o processo de congelamento?
A amostra de esperma é coletada em um local apropriado e, logo depois, é processada pela equipe especializada em andrologia. Após a preparação, os espermatozoides são guardados em recipientes especiais, submersos em nitrogênio líquido a uma temperatura de -196°C. Nessas condições, os gametas podem ser preservados por tempo indeterminado, mantendo sua capacidade de serem usados no futuro.